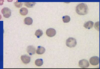

Random Infectious Disease Slides Flashcards
(20 cards)

malaria
spleen slide


white pulp of spleen



howell-jolly body – DNA remnant

heinz bodies (denatured hemoglobin)
what is this cell infected with?

malaria
what organ is marked on the CT

spleen.
compared to the normal smear, what is displayed on the below smear

spherocytes. indicative of a hemolytic disease (either hereidtery spherocytosis or autoimmune hemolytic anemia)
heinz bodies. seen in G6PD deficiency (can cause hemolytic anemia)

sickle cell disease.
a person with splenomegaly is biopsied and this is found: what is the cause of his splenomegaly?

malignant expansion of white pulp in spleen. splenomegaly is due to infiltrative/maligant cause.
causes of hyposplenism and asplenia

what inclusion is seen on this slide

howell jolly bodies. probably due to hyposplenism so the spleen cannot remove the RBC inclusions properly.

how would you manage this patient who displayed this slide? (She has an initial diagnosis of NAFLD)

liver biopsy shows fibroids in liver– cirrhosis.
management: screen for varices
- screen for HCC
- low sodium diet to prevent ascites and portal hypertension
- spironolactone/furosemide as a dieuretic
this person had autoimmune tests -. what could this be?

hereditery spherocytosis
what cell is the arrow pointing to?

atypical lymphocytes
- seen in EBV, CMB, HCV
- toxoplasmosis
- syphilis



beta thalassemia
this person pesented with jaundice, variceal bleeding and splenomegaly. liver biopsy showed this. what is it?

schistosomiasis.